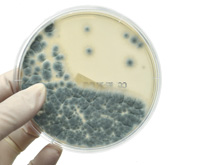

The advice hub Brooder Pneumonia
Aspergillus Infection in Chicks
Aspergillosis is a fungal disease commonly found to cause pneumonia in young chicks, hence it was frequently called “brooder pneumonia”.
Aspergillosis is caused by a fungus called Aspergillus.
This fungus can grow in the environment including in feed, bedding and in extreme situations in animal tissues. The fungus produces spores which are spread in the air going on to germinate therefore completing the fungal life cycle.
Normally the environment contains some Aspergillus spores which when inhaled by healthy adult birds and mammals are harmless. However, there are a number of factors which can tip the balance in favour of the fungus:
- An environment containing high levels spores can overwhelm the body’s natural defences which causes the disease such as day old chicks under brooders (hence the term brooder pneumonia).
- Birds with other diseases are more vulnerable to infection.
- Environmental factors such as extreme cold, high levels of ammonia or high dust levels can stress the chickens lowering their immune system. This reduces their ability to fight infection which increases the chances of developing aspergillosis.
- Antibiotic medication will result in a greater risk of development as antibiotics kill all bacteria on the surface of the respiratory tract leaving more room for fungal attachment and infection.
The fungus likes warm moist conditions in which to grow and produce spores therefore feed or bedding which has become wet then warm provides an ideal place for this fungus to grow. When this happens in a chick’s environment and is heated with brooders the spore levels can become very high and go on to produce disease in young birds.
The other common place for the fungus to grow is within eggs in the incubator. These infected eggs can burst and release high levels of spores consequently infecting the other chicks in the incubator.
Once the spores take hold the fungus grows primarily in the affected chicken’s airways causing difficulty in breathing. These chickens often gasp with their mouths open. Unlike many respiratory diseases the birds do NOT sound chesty. The fungus can spread around the body often to the nervous system and eyes causing blindness, a twisted head and paralysis.
The disease is diagnosed based upon clinical signs and post mortem with fungal cultures being used to confirm the suspicion of brooder pneumonia. On PM the birds will have white/grey/yellow nodules in their air sacs and lungs. Once infected, birds will rarely recover as there is no suitable treatment, antibiotics will not help. Such birds are best being humanely put to sleep. The next thing to do is to try and identify the primary source of the spores. It’s worth replacing the litter and feed.
Aspergillus cannot be spread from chicken to chicken but it is quite likely in a heavily contaminated environment that several birds will pick up the infection at the same time. It ought to be pointed out that Aspergillus can affect humans especially if immuno-suppressed.
The key with Aspergillus is prevention. The environment and feed should be kept clean, dry and dust-free. We recommend dust extracted shavings from a reputable source, often plastic shrink wrapped as they are hygienic. The chick environment should be cleaned and disinfected between batches of chicks. Straw and hay when damp will harbour moulds with ease.
